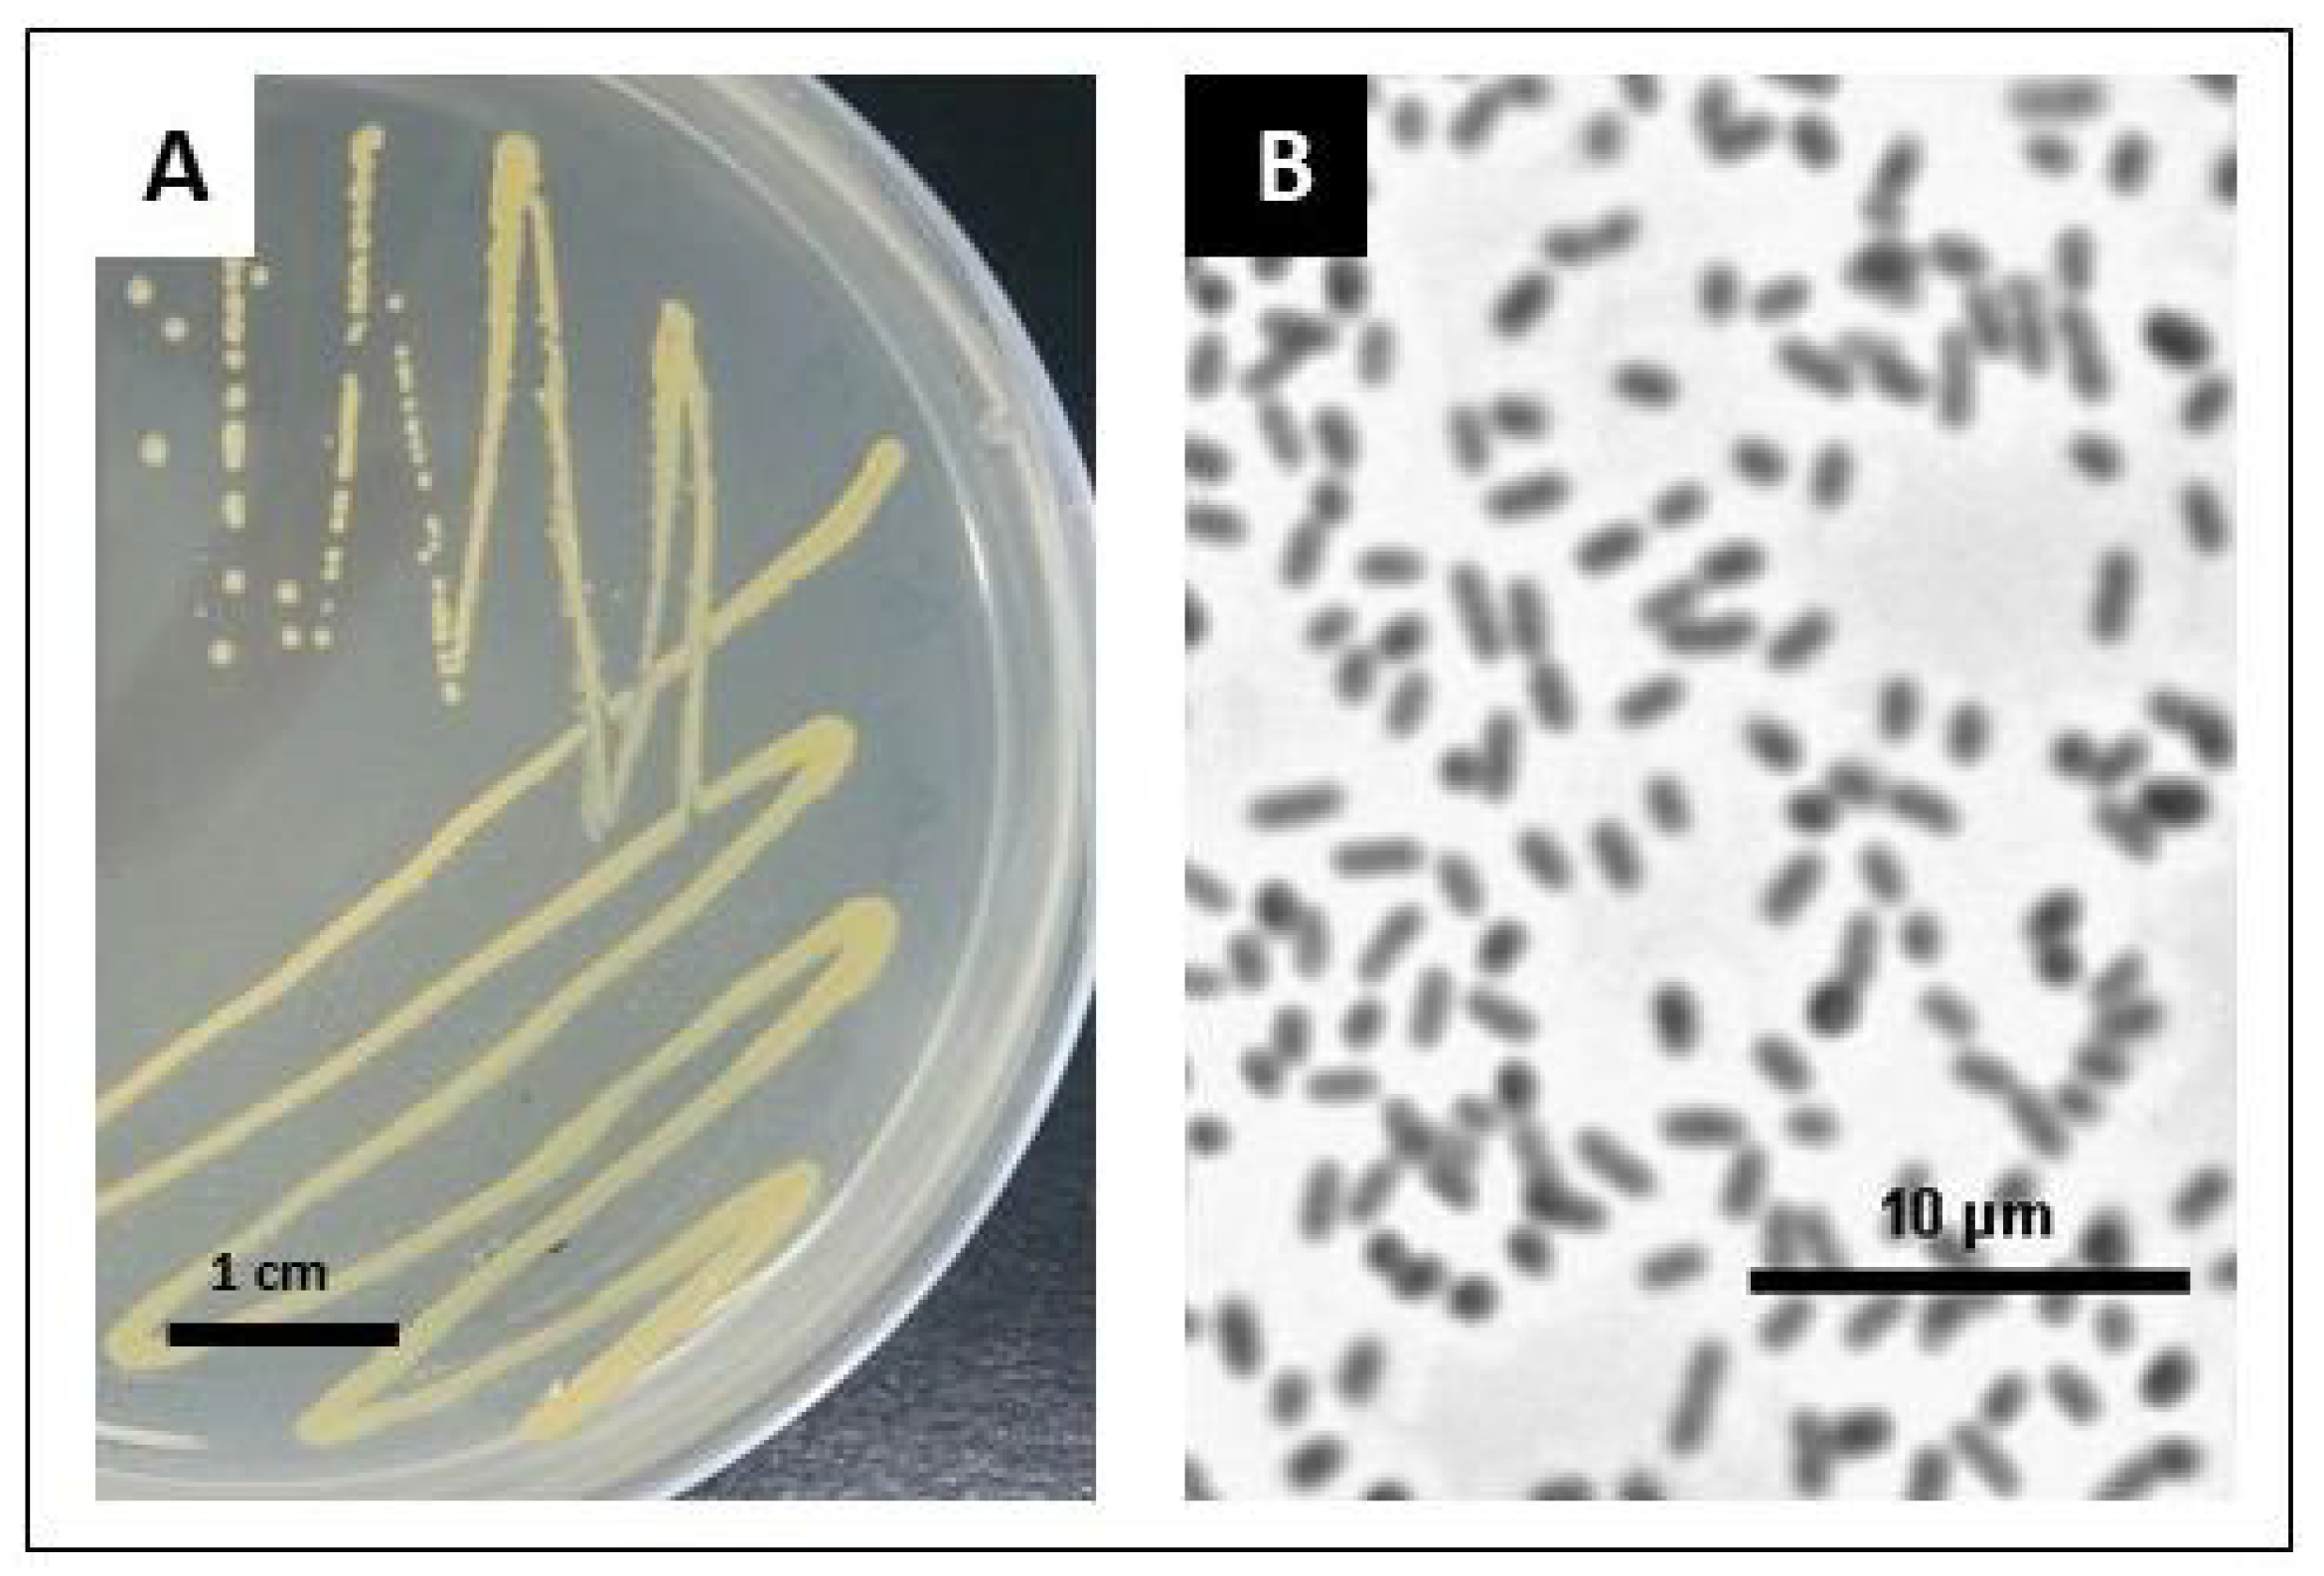
Ijms 24 02174 g001 Ijms 24 02174 g001

Seeds of Stevia rebaudiana Bertoni as a Source of Plant Growth-Promoting Endophytic Bacteria with the Potential to Synthesize Rebaudioside A
Abstract
1. Introduction
2. Results
2.1. Preliminary Identification of Endophytic Bacteria
2.2. New Strain SRS89 of Pantoea Vagans—Genome Features, Comparative Genome Analysis, and Gene Classification
2.3. Biochemical Properties of SRS89 Strain
2.4. Seed Germination Promoting Potential of SRS89 Strain
3. Discussion
4. Materials and Methods
4.1. Bacteria Isolation and Maintenance
4.2. Amplification and Sequencing of the 16S rRNA Gene
4.3. WGS Isolated Bacteria Strain and Data Analysis
4.4. HPLC Analysis of Isolated Bacteria
4.5. Mass Spectrometry Confirmation of RebA
4.6. Profiling of Plant Hormones
4.7. Effect of Endophytic Bacteria on Stevia Seed Germination
4.8. Statistical Analysis
5. Conclusions
Supplementary Materials
Author Contributions
Funding
Institutional Review Board Statement
Informed Consent Statement
Data Availability Statement
Acknowledgments
Conflicts of Interest
References
- Richman, A.; Swanson, A.; Humphrey, T.; Chapman, R.; McGarvey, B.; Pocs, R.; Brandle, J. Functional genomics uncovers three glucosyltransferases involved in the synthesis of the major sweet glucosides of Stevia rebaudiana. Plant J. 2005, 41, 56–67. [Google Scholar] [CrossRef] [PubMed]
 - Brandle, J.E.; Telmer, P.G. Steviol glycoside biosynthesis. Phytochemistry 2007, 68, 1855–1863. [Google Scholar] [CrossRef] [PubMed]
 - Guleria, P.; Yadav, S.K. Agrobacterium mediated transient gene silencing (AMTS) in Stevia rebaudiana: Insights into steviol glycoside biosynthesis pathway. PLoS ONE 2013, 8, e74731. [Google Scholar] [CrossRef]
 - Yadav, A.K.; Singh, S.; Dhyani, D.; Ahuja, P.S. A review on the improvement of stevia [Stevia rebaudiana (Bertoni)]. Can. J. Plant Sci. 2011, 91, 1–27. [Google Scholar] [CrossRef]
 - Momtazi-Borojeni, A.A.; Esmaeili, S.A.; Abdollahi, E.; Sahebkar, A. A Review on the pharmacology and toxicology of steviol glycosides extracted from Stevia rebaudiana. Curr. Pharm. Des. 2017, 23, 1616–1622. [Google Scholar] [CrossRef]
 - Peteliuk, V.; Rybchuk, L.; Bayliak, M.; Storey, K.B.; Lushchak, O. Natural sweetener Stevia rebaudiana: Functionalities, health benefits and potential risks. Excli. J. 2021, 20, 14121430. [Google Scholar] [CrossRef]
 - Ohta, M.; Sasa, S.; Inoue, A.; Tamai, T.; Fujita, I.; Morita, K.; Matsuura, F. Characterization of novel steviol glycosides from leaves of Stevia rebaudiana Morita. J. Appl. Glycosci. 2010, 57, 199–209. [Google Scholar] [CrossRef]
 - Chaturvedula, V.S.; Prakash, I. Structures of the novel diterpene glycosides from Stevia rebaudiana. Carbohydr. Res. 2011, 346, 1057–1060. [Google Scholar] [CrossRef]
 - Chaturvedula, V.S.; Prakash, I. Additional minor diterpene glycosides from Stevia rebaudiana. Nat. Prod. Commun. 2011, 6, 1059–1062. [Google Scholar] [CrossRef]
 - Chaturvedula, V.S.; Rhea, J.; Milanowski, D.; Mocek, U.; Prakash, I. Two minor diterpene glycosides from the leaves of Stevia rebaudiana. Nat. Prod. Commun. 2011, 6, 175–178. [Google Scholar] [CrossRef]
 - Ceunen, S.; Geuns, J.M.C. Steviol glycosides: Chemical diversity, metabolism, and function. J. Nat. Prod. 2013, 76, 1201–1228. [Google Scholar] [CrossRef] [PubMed]
 - Prakash, I.; Chaturvedula, V.S.P. Steviol glycosides: Natural noncaloric sweeteners. In Sweeteners: Pharmacology, Biotechnology, and Applications; Mérillon, J.-M., Ramawat, K.G., Eds.; Springer: Cham, Switzerland, 2018; Volume 5, pp. 101–128. [Google Scholar]
 - DuBois, G.E.; Stephenson, R.A. Diterpenoid sweeteners. Synthesis and sensory evaluation of stevioside analogs with improved organoleptic properties. J. Med. Chem. 1985, 28, 93–98. [Google Scholar] [CrossRef] [PubMed]
 - Li, P.; Wang, Z.; Lam, S.M.; Shui, G. Rebaudioside A enhances pesistance to oxidative stress and extends lifespan and healthspan in Caenorhabditis elegans. Antioxidants 2021, 10, 262. [Google Scholar] [CrossRef] [PubMed]
 - Wang, Y.; Luo, X.; Chen, L.; Mustapha, A.T.; Yu, X.; Zhou, C.; Okonkwo, C.E. Natural and low-caloric rebaudioside A as a substitute for dietary sugars: A comprehensive review. Compr. Rev. Food Sci. Food Saf. 2023, 22, 615–642. [Google Scholar] [CrossRef] [PubMed]
 - Nettleton, J.E.; Klancic, T.; Schick, A.; Choo, A.C.; Shearer, J.; Borgland, S.L.; Chleilat, F.; Mayengbam, S.; Reimer, R.A. Low-dose stevia (rebaudioside A) consumption perturbs gut microbiota and the mesolimbic dopamine reward system. Nutrients 2019, 11, 1248. [Google Scholar] [CrossRef]
 - Kasti, A.N.; Nikolaki, M.D.; Synodinou, K.D.; Katsas, K.N.; Petsis, K.; Lambrinou, S.; Pyrousis, I.A.; Triantafyllou, K. The effects of stevia consumption on gut bacteria: Friend or foe? Microorganisms 2022, 10, 744. [Google Scholar] [CrossRef]
 - Bondarev, N.; Sukhanova, M.; Reshetnyak, O.; Nosov, A.M. Steviol glycoside content in different organs of Stevia rebaudiana and its dynamics during ontogeny. Biol. Plant 2003, 47, 261–264. [Google Scholar] [CrossRef]
 - Kang, K.H.; Lee, E.W. Physio-ecological studies on stevia (Stevia rebaudiana Bertoni). Korean J. Crop. Sci. 1981, 26, 69–89. [Google Scholar]
 - Tavarini, S.; Sgherri, C.; Ranieri, A.M.; Angelini, L.G. Effect of nitrogen fertilization and harvest time on steviol glycosides, flavonoid composition, and antioxidant properties in Stevia rebaudiana Bertoni. J. Agric. Food Chem. 2015, 63, 7041–7050. [Google Scholar] [CrossRef]
 - Abdullateef, R.A.; Osman, M. Effects of visible light wavelengths on seed germinability in Stevia rebaudiana Bertoni. Int. J. Biol. 2011, 3, 83–91. [Google Scholar] [CrossRef]
 - Kumar, R.; Sharma, S. Effect of light and temperature on seed germination of important medicinal and aromatic plants in north western Himalayas. Int. J. Med. Arom. Plants 2012, 2, 468–475. [Google Scholar]
 - Simlat, M.; Ślęzak, P.; Moś, M.; Warchoł, M.; Skrzypek, E.; Ptak, A. The effect of light quality on seed germination, seedling growth and selected biochemical properties of Stevia rebaudiana Bertoni. Sci. Hortic. 2016, 211, 295–304. [Google Scholar] [CrossRef]
 - Simlat, M.; Ptak, A.; Skrzypek, E.; Warchoł, M.; Morańska, E.; Piórkowska, E. Melatonin significantly influences seed germination and seedling growth of Stevia rebaudiana Bertoni. PeerJ 2018, 6, e5009. [Google Scholar] [CrossRef] [PubMed]
 - Simlat, M.; Skrzypek, E.; Warchoł, M.; Maciaszek, I.; Ptak, A. Evaluation on Stevia rebaudiana Bertoni seed germination and seedling development under phytohormones treatment. Sci. Hortic. 2019, 257, 108717. [Google Scholar] [CrossRef]
 - Simlat, M.; Szewczyk, A.; Ptak, A. Melatonin promotes seed germination under salinity and enhances the biosynthesis of steviol glycosides in Stevia rebaudiana Bertoni leaves. PLoS ONE 2020, 15, e0230755. [Google Scholar] [CrossRef]
 - Puente, M.E.; Li, C.Y.; Bashan, Y. Endophytic bacteria in cacti seeds can improve the development of cactus seedlings. Environ. Exp. Bot. 2009, 66, 402–408. [Google Scholar] [CrossRef]
 - Brader, G.; Compant, S.; Vescio, K.; Mitter, B.; Trognitz, F.; Ma, L.-J.; Sessitsch, A. Ecology and genomic insights into plant-pathogenic and plant-nonpathogenic endophytes. Annu. Rev. Phytopathol. 2017, 55, 61–83. [Google Scholar] [CrossRef]
 - Smith, S.A.; Tank, D.C.; Boulanger, L.-A.; Bascom-Slack, C.A.; Eisenman, K.; Kingery, D.; Babbs, B.; Fenn, K.; Greene, J.S.; Hann, B.D.; et al. Bioactive endophytes warrant intensified exploration and conservation. PLoS ONE 2008, 3, e3052. [Google Scholar] [CrossRef] [PubMed]
 - Coleman-Derr, D.; Tringe, S.G. Building the crops of tomorrow: Advantages of symbiont-based approaches to improving abiotic stress tolerance. Front. Microbiol. 2014, 5, 283. [Google Scholar] [CrossRef] [PubMed]
 - Rosenblueth, M.; Martínez-Romero, E. Bacterial endophytes and their interactions with hosts. Mol. Plant Microbe. Interact. 2006, 19, 827–837. [Google Scholar] [CrossRef]
 - Kobayashi, D.Y.; Palumbo, J.D. Bacterial endophytes and their effects on plants and uses in agriculture. In Microbial Endophytes; Bacon, C.W., White, J.F., Eds.; Marcel Dekker, Inc.: New York, NY, USA, 2000; pp. 199–233. [Google Scholar]
 - Elmagzob, A.A.H.; Ibrahim, M.M.; Zhang, G.F. Seasonal diversity of endophytic bacteria associated with Cinnamomum camphora (L.). Presl. Diversity 2019, 11, 112. [Google Scholar] [CrossRef]
 - Anjum, N.; Chandra, R. Endophytic bacteria: Optimization of isolation procedure from various medicinal plants and their preliminary characterization. Asian J. Pharm. Clin. Res. 2015, 8, 233–238. [Google Scholar]
 - Oviedo-Pereira, D.G.; López-Meyer, M.; Evangelista-Lozano, S.; Sarmiento-López, L.G.; Sepúlveda-Jiménez, G.; Rodríguez-Monroy, M. Enhanced specialized metabolite, trichome density, and biosynthetic gene expression in Stevia rebaudiana (Bertoni) Bertoni plants inoculated with endophytic bacteria Enterobacter hormaechei. PeerJ 2022, 10, e13675. [Google Scholar] [CrossRef] [PubMed]
 - Yu, X.; Yang, J.; Wang, E.; Li, B.; Yuan, H. Effects of growth stage and fulvic acid on the diversity and dynamics of endophytic bacterial community in Stevia rebaudiana Bertoni leaves. Front. Microbiol. 2015, 6, 867. [Google Scholar] [CrossRef] [PubMed]
 - Ferreira, A.; Quecine, M.C.; Lacava, P.T.; Oda, S.; Azevedo, J.L.; Araújo, W.L. Diversity of endophytic bacteria from Eucalyptus species seeds and colonization of seedlings by Pantoea agglomerans. FEMS Microbiol. Lett. 2008, 287, 8–14. [Google Scholar] [CrossRef] [PubMed]
 - Johnston-Monje, D.; Raizada, M.N. Conservation and diversity of seed associated endophytes in Zea across boundaries of evolution, ethnography and ecology. PLoS ONE 2011, 6, e20396. [Google Scholar] [CrossRef]
 - Rijavec, T.; Lapanje, A.; Dermastia, M.; Rupnik, M. Isolation of bacterial endophytes from germinated maize kernels. Can. J. Microbiol. 2007, 53, 802–808. [Google Scholar] [CrossRef]
 - Walitang, D.I.; Kim, K.; Madhaiyan, M.K.; Kim, Y.K.; Kang, Y.; Sa, T. Characterizing endophytic competence and plant growth promotion of bacterial endophytes inhabiting the seed endosphere of Rice. BMC Microbiol. 2017, 17, 209. [Google Scholar] [CrossRef]
 - Shahzad, R.; Khan, A.L.; Saqib, B.; Sajjad, A.; In-Jung, L. What is there in seeds? Vertically transmitted endophytic resources for sustainable improvement in plant growth. Front. Plant Sci. 2018, 9, 24. [Google Scholar] [CrossRef]
 - Tyc, O.; Putra, R.; Gols, R.; Harvey, J.A.; Garbeva, P. The ecological role of bacterial seed endophytes associated with wild cabbage in the United Kingdom. MicrobiologyOpen 2020, 9, e00954. [Google Scholar] [CrossRef]
 - Zhu, B.; Chen, M.; Lin, L.; Yang, L.; Li, Y.; An, Q. Genome sequence of Enterobacter sp. strain SP1, an endophytic nitrogen-fixing bacterium isolated from sugarcane. J. Bacteriol. 2012, 194, 6963–6964. [Google Scholar] [CrossRef] [PubMed]
 - Lin, L.; Wei, C.; Chen, M.; Wang, H.; Li, Y.; Li, Y.; Yang, L.; An, Q. Complete genome sequence of endophytic nitrogen-fixing Klebsiella variicola strain DX120E. Stand. Genom. Sci. 2015, 10, 22. [Google Scholar] [CrossRef]
 - Ji, S.H.; Gururanib, M.A.; Chun, S.C. Isolation and characterization of plant growth promoting endophytic diazotrophic bacteria from Korean rice cultivars. Microbiol. Res. 2014, 169, 83–98. [Google Scholar] [CrossRef] [PubMed]
 - Qin, S.; Zhang, Y.J.; Yuan, B.; Xu, Y.P.; Xing, K.; Wang, J.; Jiang, J.-H. Isolation of ACC deaminase-producing habitat-adapted symbiotic bacteria associated with halophyte Limonium sinense (Girard) Kuntze and evaluating their plant growth-promoting activity under salt stress. Plant Soil. 2014, 374, 753–766. [Google Scholar] [CrossRef]
 - Khan, A.L.; Waqas, M.; Kang, S.M.; Al-Harrasi, A.; Hussain, J.; Al-Rawahi, A.; Al-Khiziri, S.; Ullah, I.; Ali, L.; Jung, H.Y.; et al. Bacterial endophyte Sphingomonas sp. LK11 produces gibberellins and IAA and promotes tomato plant growth. J. Microbiol. 2014, 52, 689–695. [Google Scholar] [CrossRef] [PubMed]
 - Yan, X.; Wang, Z.; Mei, Y.; Wang, L.; Wang, X.; Xu, Q.; Peng, S.; Zhou, Y.; Wei, C. Isolation, diversity, and growth-promoting activities of endophytic bacteria from tea cultivars of Zijuan and Yunkang-10. Front. Microbiol. 2018, 9, 1848. [Google Scholar] [CrossRef]
 - Chen, C.; Xin, K.; Liu, H.; Cheng, J.; Shen, X.; Wang, Y.; Zhang, L. Pantoea alhagi, a novel endophytic bacterium with ability to improve growth and drought tolerance in wheat. Sci. Rep. 2017, 7, 41564. [Google Scholar] [CrossRef]
 - Wu, W.; Chen, W.; Liu, S.; Wu, J.; Zhu, Y.; Qin, L.; Zhu, B. Beneficial relationships between endophytic bacteria and medicinal plants. Front. Plant Sci. 2021, 12, 646146. [Google Scholar] [CrossRef]
 - Lacava, P.T.; Azevedo, J.L. Endophytic bacteria: A biotechnological potential in agrobiology system. In Bacteria in Agrobiology: Crop Productivity; Maheshwari, D.K., Saraf, M., Aeron, A., Eds.; Springer-Verlag: Berlin/Heidelberg, Germany, 2013; pp. 1–44. [Google Scholar]
 - Walterson, A.M.; Stavrinides, J. Pantoea: Insights into a highly versatile and diverse genus within the Enterobacteriaceae. FEMS Microbiol. Rev. 2015, 39, 968–984. [Google Scholar] [CrossRef]
 - Pusey, P.L. Biological control agents for fire blight of apple compared under conditions limiting natural dispersal. Plant Dis. 2002, 86, 639–644. [Google Scholar] [CrossRef]
 - Herrera, S.D.; Grossi, C.; Zawoznik, M.; Groppa, M.D. Wheat seeds harbour bacterial endophytes with potential as plant growth promoters and biocontrol agents of Fusarium graminearum. Microbiol. Res. 2016, 186–187, 37–43. [Google Scholar] [CrossRef] [PubMed]
 - Lorenzi, A.S.; Bonatelli, M.L.; Chia, M.A.; Peressim, L.; Quecine, M.C. Opposite sides of Pantoea agglomerans and its associated commercial outlook. Microorganisms 2022, 10, 2072. [Google Scholar] [CrossRef] [PubMed]
 - Lv, L.; Luo, J.; Ahmed, T.; Zaki, H.E.M.; Tian, Y.; Shahid, M.S.; Chen, J.; Li, B. Beneficial effect and potential risk of Pantoea on rice production. Plants 2022, 11, 2608. [Google Scholar] [CrossRef] [PubMed]
 - Tambong, J.T. Taxogenomics and systematics of the genus Pantoea. Front. Microbiol. 2019, 10, 2463. [Google Scholar] [CrossRef] [PubMed]
 - Palmer, M.; de Maayer, P.; Poulsen, M.; Steenkamp, E.T.; van Zyl, E.; Coutinho, T.A.; Venter, S.N. Draft genome sequences of Pantoea agglomerans and Pantoea vagans isolates associated with termites. Stand Genomic. Sci. 2016, 11, 23. [Google Scholar] [CrossRef]
 - Sheibani-Tezerji, R.; Naveed, M.; Jehl, M.A.; Sessitsch, A.; Rattei, T.; Mitter, B. The genomes of closely related Pantoea ananatis maize seed endophytes having different effects on the host plant differ in secretion system genes and mobile genetic elements. Front. Microbiol. 2015, 6, 440. [Google Scholar] [CrossRef]
 - Kim-Dura, S.; Lowman, S.; Zhang, S.; Mei, C. Growth promotion of switchgrass by bacterial endophyte Pantoea agglomerans strain PaKM isolated from seeds. J. Path. Microbiol. 2016, 1, 1007. [Google Scholar]
 - Smits, T.H.; Rezzonico, F.; Kamber, T.; Goesmann, A.; Ishimaru, C.A.; Stockwell, V.O.; Frey, J.E.; Duffy, B. Genome sequence of the biocontrol agent Pantoea vagans strain C9-1. J. Bacteriol. 2010, 192, 6486–6487. [Google Scholar] [CrossRef]
 - Feng, Y.; Shen, D.; Song, W. Rice endophyte Pantoea agglomerans YS19 promotes host plant growth and affects allocations of host photosynthates. J. Appl. Microbiol. 2006, 100, 938–945. [Google Scholar] [CrossRef]
 - Omer, Z.S.; Björkman, P.-O.; Nicander, B.; Tillberg, E.; Gerhardson, B. 5′-Deoxyisopentenyladenosine and other cytokinins in culture filtrates of the bacterium Pantoea agglomerans. Physiol. Plant 2004, 121, 439–447. [Google Scholar] [CrossRef]
 - Trifi, H.; Ben Salem, I.; Benzina, K.; Fourati, A.; Costa, M.C.; Achouak, W.; Saidi, M. Effectiveness of the plant growth-promoting rhizobacterium Pantoea sp. BRM17 in enhancing Brassica napus growth in phosphogypsum-amended soil. Pedosphere 2017, 30, 4. [Google Scholar] [CrossRef]
 - Kim, S.-N.; Cho, W.-K.; Kim, W.-I.; Jee, H.-J.; Park, C.-S. Growth promotion of pepper plants by Pantoea ananatis B1-9 and its efficient endophytic colonization capacity in pant tissues. Plant Pathol. J. 2012, 28, 270–281. [Google Scholar] [CrossRef]
 - Atzorn, R.; Crozier, A.; Wheeler, C.T.; Sandberg, G. Production of gibberellins and indole-3-acetic acid by Rhizobium phaseoli in relation to nodulation of Phaseolus vulgaris roots. Planta 1988, 175, 532–538. [Google Scholar] [CrossRef] [PubMed]
 - Bottini, R.; Fulchieri, M.; Pearce, D.; Pharis, R.P. Identification of gibberellins A1, A3, and Iso-A3 in cultures of Azospirillum lipoferum. Plant Physiol. 1989, 90, 45–47. [Google Scholar] [CrossRef]
 - Bastian, F.; Cohen, A.; Piccoli, P.; Luna, V.; Baraldi, R.; Bottini, R. Production of indole-3-acetic acid and gibberellins A1 and A3 by Acetobacter diazotrophicus and Herbaspirillum seropedicae in chemically-defined culture media. Plant Growth Regul. 1998, 24, 7–11. [Google Scholar] [CrossRef]
 - Kang, S.M.; Joo, G.J.; Hamayun, M.; Na, C.I.; Shin, D.H.; Kim, H.Y.; Lee, I.J. Gibberellin production and phosphate solubilization by newly isolated strain of Acinetobacter calcoaceticus and its effect on plant growth. Biotechnol. Lett. 2009, 31, 277–281. [Google Scholar] [CrossRef]
 - Kang, S.M.; Khan, A.L.; You, Y.H.; Kim, J.G.; Kamran, M.; Lee, I.J. Gibberellin production by newly isolated strain Leifsonia soli SE134 and its potential to promote plant growth. J. Microbiol. Biotechnol. 2014, 24, 106–112. [Google Scholar] [CrossRef]
 - Joo, G.J.; Kim, Y.M.; Kim, J.T.; Rhee, I.K.; Kim, J.H.; Lee, I.J. Gibberellins-producing rhizobacteria increase endogenous gibberellins content and promote growth of red peppers. J. Microbiol. 2005, 43, 510–515. [Google Scholar]
 - Joo, G.J.; Kang, S.M.; Hamayun, M.; Kim, S.K.; Na, C.I.; Shin, D.H.; Lee, I.J. Burkholderia sp. KCTC 11096BP as a newly isolated gibberellin producing bacterium. J. Microbiol. 2009, 47, 167–171. [Google Scholar] [CrossRef]
 - Salazar-Cerezo, S.; Martínez-Montiel, N.; García-Sánchez, J.; Pérez-y-Terrón, R.; Martínez-Contreras, R.D. Gibberellin biosynthesis and metabolism: A convergent route for plants, fungi and bacteria. Microbiol. Res. 2018, 208, 85–98. [Google Scholar] [CrossRef]
 - Nett, R.S.; Montanares, M.; Marcassa, A.; Lu, X.; Nagel, R.; Charles, T.C.; Hedden, P.; Rojas, M.C.; Peters, R.J. Elucidation of gibberellin biosynthesis in bacteria reveals convergent evolution. Nat. Chem. Biol. 2017, 13, 69–74. [Google Scholar] [CrossRef] [PubMed]
 - Olsson, K.; Carlsen, S.; Semmler, A.; Simón, E.; Mikkelsen, M.D.; Møller, B.L. Microbial production of next-generation stevia sweeteners. Microb. Cell Fact. 2016, 15, 207. [Google Scholar] [CrossRef]
 - Wang, J.; Li, S.; Xiong, Z.; Wang, Y. Pathway mining-based integration of critical enzyme parts for de novo biosynthesis of steviol glycosides sweetener in Escherichia coli. Cell Res. 2016, 26, 258–261. [Google Scholar] [CrossRef] [PubMed]
 - Moon, J.H.; Lee, K.; Lee, J.H.; Lee, P.C. Redesign and reconstruction of a steviol-biosynthetic pathway for enhanced production of steviol in Escherichia coli. Microb. Cell Fact. 2020, 19, 20. [Google Scholar] [CrossRef]
 - Guo, B.; Hou, X.; Zhang, Y.; Deng, Z.; Ping, Q.; Fu, K.; Yuan, Z.; Rao, Y. Highly efficient production of rebaudioside D enabled by structure-guided engineering of bacterial glycosyltransferase YojK. Front. Bioeng. Biotechnol. 2022, 10, 985826. [Google Scholar] [CrossRef] [PubMed]
 - Eljounaidi, K.; Lee, S.K.; Bae, H. Bacterial endophytes as potential biocontrol agents of vascular wilt diseases—Review and future prospects. Biol. Control. 2016, 103, 62–68. [Google Scholar] [CrossRef]
 - Ptak, A.; Morańska, E.; Warchoł, M.; Gurgul, A.; Skrzypek, E.; Dziurka, M.; Laurain-Mattar, D.; Spina, R.; Jaglarz, A.; Simlat, M. Endophytic bacteria from in vitro culture of Leucojum aestivum L. a new source of galanthamine and elicitor of alkaloid biosynthesis. Sci. Rep. 2022, 12, 13700. [Google Scholar] [CrossRef]
 - Ali, S.; Charles, T.C.; Glick, B.R. Amelioration of high salinity stress damage by growth-promoting bacterial endophytes that contain ACC deaminase. Plant Physiol. Biochem. 2014, 80, 160–167. [Google Scholar] [CrossRef]
 - Fikri, A.S.I.; Rahman, I.A.; Nor, N.S.M.; Hamzah, A. Isolation and identification of local bacteria endophyte and screening of its antimicrobial property against pathogenic bacteria and fungi. AIP Conf. Proc. 2018, 1940, 020072. [Google Scholar] [CrossRef]
 - Ek-Ramos, M.J.; Gomez-Flores, R.; Orozco-Flores, A.A.; Rodríguez-Padilla, C.; González-Ochoa, G.; Tamez-Guerra, P. Bioactive products from plant-endophytic gram-positive bacteria. Front. Microbiol. 2019, 10, 463. [Google Scholar] [CrossRef]
 - Munakata, Y.; Gavira, C.; Genestier, J.; Bourgaud, F.; Hehn, A.; Slezack-Deschaumes, S. Composition and functional comparison of vetiver root endophytic microbiota originating from different geographic locations that show antagonistic activity towards Fusarium graminearum. Microbiol. Res. 2021, 243, 126650. [Google Scholar] [CrossRef] [PubMed]
 - Joseph, B.; Mini Priya, R. Bioactive compounds from endophytes and their potential in pharmaceutical effect: A Review. Am. J. Biochem. Mol. Biol. 2011, 1, 291–309. [Google Scholar] [CrossRef]
 - Singh, M.; Kumar, A.; Singh, R.; Pandey, K.D. Endophytic bacteria: A new source of bioactive compounds. 3 Biotech 2017, 7, 315. [Google Scholar] [CrossRef]
 - Basit, A.; Shah, S.T.; Ullah, I.; Ullah, I.; Mohamed, H.I. Microbial bioactive compounds produced by endophytes (bacteria and fungi) and their uses in plant health. In Plant Growth-Promoting Microbes for Sustainable Biotic and Abiotic Stress Management; Mohamed, H.I., El-Beltagi, H.E.-D.S., Abd-Elsalam, K.A., Eds.; Springer: Cham, Switzerland, 2021; pp. 285–318. [Google Scholar] [CrossRef]
 - Rochín-Hernández, L.S.; Rochín-Hernández, L.J.; Flores-Cotera, L.B. Endophytes, a potential source of bioactive compounds to curtail the formation–accumulation of advanced glycation end products: A Review. Molecules 2022, 27, 4469. [Google Scholar] [CrossRef]
 - Periche, A.; Koutsidis, G.; Escriche, I. Composition of antioxidants and amino acids in stevia leaf infusions. Plant Foods Hum. Nutr. 2014, 69, 1–7. [Google Scholar] [CrossRef] [PubMed]
 - Chandra, S.; Askari, K.; Kumari, M. Optimization of indole acetic acid production by isolated bacteria from Stevia rebaudiana rhizosphere and its effects on plant growth. J. Genet. Eng. Biotechnol. 2018, 16, 581–586. [Google Scholar] [CrossRef] [PubMed]
 - Kim, Y.C.; Leveau, J.; Gardener, B.B.M.; Pierson, E.A.; Pierson, L.S.; Ryu, C.-M. The multifactorial basis for plant health promotion by plant-associated bacteria. Appl. Environ. Microb. 2011, 77, 1548–1555. [Google Scholar] [CrossRef]
 - Strader, L.C.; Culler, A.H.; Cohen, J.D.; Bartel, B. Conversion of endogenous indole-3-butyric acid to indole-3-acetic acid drives cell expansion in Arabidopsis seedlings. Plant Physiol. 2010, 153, 1577–1586. [Google Scholar] [CrossRef]
 - Avanci, N.C.; Luche, D.D.; Goldman, G.H.; Goldman, M.H. Jasmonates are phytohormones with multiple functions, including plant defense and reproduction. Genet. Mol. Res. 2010, 9, 484–505. [Google Scholar] [CrossRef]
 - Eng, F.; Marin, J.E.; Zienkiewicz, K.; Gutiérrez-Rojas, M.; Favela-Torres, E.; Feussner, I. Jasmonic acid biosynthesis by fungi: Derivatives, first evidence on biochemical pathways and culture conditions for production. PeerJ 2021, 9, e10873. [Google Scholar] [CrossRef]
 - Quecine, M.; Araújo, W.L.; Rossetto, P.B.; Ferreira, A.; Tsui, S.; Lacava, P.; Mondin, M.; Azevedo, J.L.; Pizzirani-Kleiner, A.A. Sugarcane growth promotion by the endophytic bacterium Pantoea agglomerans 33. 1. Appl. Environ. Microbiol. 2012, 78, 7511–7518. [Google Scholar] [CrossRef] [PubMed]
 - Du Jardin, P. Plant biostimulants: Definition, concept, main categories and regulation. Sci. Hortic. 2015, 196, 3–14. [Google Scholar] [CrossRef]
 - Angelini, L.G.; Martini, A.; Passera, B.; Tavarini, S. Cultivation of Stevia rebaudiana Bertoni and Associated Challenges. In Sweeteners; Mérillon, J.M., Ramawat, K., Eds.; Reference Series in Phytochemistry; Springer: Cham, Switzerland, 2018; pp. 35–85. [Google Scholar]
 - Bharti, N.; Pandey, S.; Barnawal, D.; Patel, V.K.; Kalra, A. Plant growth promoting rhizobacteria Dietzia natronolimnaea modulates the expression of stress responsive genes providing protection of wheat from salinity stress. Sci. Rep. 2016, 6, 34768. [Google Scholar] [CrossRef] [PubMed]
 - Marchesi, J.R.; Sato, T.; Weightman, A.J.; Martin, T.A.; Fry, J.C.; Hiom, S.J.; Dymock, D.; Wade, W.G. Design and evaluation of useful bacterium-specific PCR primers that amplify genes coding for bacterial 16S rRNA. Appl. Environ. Microbiol. 1998, 64, 795–799. [Google Scholar] [CrossRef] [PubMed]
 - Bolger, A.M.; Lohse, M.; Usadel, B. Trimmomatic: A flexible trimmer for Illumina sequence data. Bioinformatics 2014, 30, 2114–2210. [Google Scholar] [CrossRef] [PubMed]
 - Wick, R.R.; Judd, L.M.; Gorrie, C.L.; Holt, K.E. Unicycler: Resolving bacterial genome assemblies from short and long sequencing reads. PLoS Comput. Biol. 2017, 13, e1005595. [Google Scholar] [CrossRef]
 - Bankevich, A.; Nurk, S.; Antipov, D.; Gurevich, A.A.; Dvorkin, M.; Kulikov, A.S.; Lesin, V.M.; Nikolenko, S.I.; Pham, S.; Prjibelski, A.D.; et al. SPAdes: A new genome assembly algorithm and its applications to single-cell sequencing. J. Comput. Biol. 2012, 19, 455–477. [Google Scholar] [CrossRef]
 - Walker, B.; Abeel, T.; Shea, T.; Priest, M.; Abouelliel, A.; Sakthikumar, S.; Cuomo, C.A.; Zeng, Q.; Wortman, J.; Young, S.K.; et al. Pilon: An integrated tool for comprehensive microbial variant detection and genome assembly improvement. PLoS ONE 2014, 9, e112963. [Google Scholar] [CrossRef]
 - Gurevich, A.; Saveliev, V.; Vyahhi, N.; Tesler, G. QUAST: Quality assessment tool for genome assemblies. Bioinformatics 2013, 29, 1072–1075. [Google Scholar] [CrossRef]
 - Aziz, R.K.; Bartels, D.; Best, A.A.; DeJongh, M.; Disz, T.; Edwards, R.A.; Formsma, K.; Gerdes, S.; Glass, E.M.; Kubal, M.; et al. The RAST Server: Rapid annotations using subsystems technology. BMC Genomics. 2008, 8, 75. [Google Scholar] [CrossRef]
 - Taboada, B.; Estrada, K.; Ciria, R.; Merino, E. Operon-mapper: A web server for precise operon identification in bacterial and archaeal genomes. Bioinformatics 2018, 34, 4118–4120. [Google Scholar] [CrossRef]
 - Darling, A.C.; Mau, B.; Blattner, F.R.; Perna, N.T. Mauve: Multiple alignment of conserved genomic sequence with rearrangements. Genome Res. 2004, 14, 1394–1403. [Google Scholar] [CrossRef] [PubMed]
 - Bosi, E.; Donati, B.; Galardini, M.; Brunetti, S.; Sagot, M.F.; Lió, P.; Crescenzi, P.; Fani, R.; Fondi, M. MeDuSa: A multi-draft based scaffolder. Bioinformatics 2015, 31, 2443–2451. [Google Scholar] [CrossRef]
 - Chaudhari, N.; Gupta, V.; Dutta, C. BPGA- an ultra-fast pan-genome analysis pipeline. Sci. Rep. 2016, 6, 24373. [Google Scholar] [CrossRef]
 - Hura, T.; Dziurka, M.; Hura, K.; Ostrowska, A.; Dziurka, K.; Gadzinowska, J. Wheat and rye genome confer specific phytohormone profile features and interplay under water stress in two phenotypes of triticale. Plant Physiol. Biochem. 2017, 118, 494–509. [Google Scholar] [CrossRef] [PubMed]
 - Dziurka, K.; Dziurka, M.; Muszyńska, E.; Czyczyło-Mysza, I.; Warchoł, M.; Juzoń, K.; Laskoś, K.; Skrzypek, E. Anatomical and hormonal factors determining the development of haploid and zygotic embryos of oat (Avena sativa L.). Sci. Rep. 2022, 12, 1–13. [Google Scholar] [CrossRef]

| Statistics | |
|---|---|
| # contigs | 151 | 
| # contigs (≥0 bp) | 158 | 
| # contigs (≥1000 bp) | 143 | 
| Largest contig | 175,366 | 
| Total length | 4,610,019 | 
| Total length (≥0 bp) | 4,611,133 | 
| Total length (≥1000 bp) | 4,606,440 | 
| N50 | 57,973 | 
| N75 | 28,681 | 
| L50 | 23 | 
| L75 | 51 | 
| GC (%) | 55.26 | 
| Mismatches | |
| #N’s | 0 | 
| #N’s per 100 kbp | 0 | 
| No. | Strain | Genome Size (bp) | Number of CDS | Genomic G+C % | Pan-Genome Size | No. of Core Genes | No. of Accessory Genes | No. of  Unique Genes  | No. of Exclusively Absent Genes | 
|---|---|---|---|---|---|---|---|---|---|
| 1 | SRS89 | 4,610,019 | 4204 | 55.3 | 5562 | 3352 | 451 | 159 | 85 | 
| 2 | C9-1 | 4,888,338 | 4354 | 55.1 | 619 | 205 | 43 | ||
| 3 | MP7 | 4,598,703 | 4005 | 55.1 | 484 | 102 | 17 | ||
| 4 | FDAARGOS_160 | 4,808,855 | 4335 | 55.2 | 475 | 349 | 111 | ||
| 5 | LMG 24199 | 4,790,329 | 4318 | 55.3 | 594 | 188 | 8 | ||
| 6 | PV989 | 4,839,154 | 4397 | 55.3 | 571 | 264 | 19 | 
| Steviol Glycosides | Content [mg/g of DW] ± SD | 
|---|---|
| stevioside (ST) | nd | 
| rebaudioside A (Reb A) | 4.41 ± 0.21 | 
| Amino acids | Content [mg/g of DW] ± SD | 
| phenylalanine | 0.75 ± 0.13 | 
| tryptophan | 0.57 ± 0.07 | 
| Growth regulators | Content [pg/g of DW] ± SD | 
| indole-3-carboxylic acid (I3CA) | 3716.6 ± 166.2 | 
| indole-3-acetic acid (IAA) | 831.7 ± 68.4 | 
| indole-3-acetyl-aspartic acid (IAAsp) | 112.0 ± 16.6 | 
| indole-3-acetamid (IAM) | ta | 
| oxoindole-3-acetic acid (OxIAA) | ta | 
| indole-3-acetyl-glutamic acid (IAGlu) | ta | 
| indole-3-acetonitril (IAN) | ta | 
| indole-3-propionic acid (IPA) | ta | 
| GA3 | 17,402.2 ± 292.8 | 
| GA6 | 318.3 ± 78.3 | 
| GA1 | ta | 
| GA4 | ta | 
| GA19 | ta | 
| GA44 | ta | 
| GA53 | ta | 
| jasmonic acid (JA) | 213.2 ± 48.3 | 
| salicylic acid (SA) | 1830.8 ± 231.7 | 
| benzoic acid (BeA) | 10,770.4 ± 426.6 | 
| abscisic acid (ABA) | ta | 
| Compound | Type of Ion | Transition (Precursor/Product Ions)  | Fragmentor Voltage (V) | Collision Energy (V) | |
|---|---|---|---|---|---|
| D-BeA | ISTD | [M+H]+ | 128.1/84.2 | 60 | 13 | 
| BeA | [M+H]+ | 124.1/80.0 | 60 | 13 | |
| D-SA | ISTD | [M+H]+ | 143.2/125.2 | 80 | 13 | 
| 143.2/69.1 | 29 | ||||
| SA | [M+H]+ | 139.2/121.2 | 80 | 13 | |
| 139.2/65.1 | 29 | ||||
| D-JA | ISTD | [M+H]+ | 216.3/153.2 | 80 | 5 | 
| 216.3/135.2 | 9 | ||||
| JA | [M+H]+ | 211.3/151.2 | 80 | 14 | |
| 211.3/133.2 | 14 | ||||
| D-IAA | ISTD | [M+H]+ | 181.1/135.1 | 38 | 14 | 
| 181.1/82.1 | 53 | ||||
| IAA | [M+H]+ | 176.1/130.3 | 51 | 9 | |
| 176.1/77.2 | 53 | ||||
| I3CA | [M+H]+ | 162.2/118.1 | 58 | 9 | |
| 162.2/89.1 | 37 | ||||
| IAA-Asp | [M+H]+ | 291.2/130.1 | 54 | 13 | |
| 291.2/77.1 | 81 | ||||
| GA3 | [M-H2O+H]+ | 329.3/283.3 | 100 | 14 | |
| 329.3/311.3 | 14 | ||||
| D-GA1 | ISTD | [M-H2O+H]+ | 333.3/287.2 | 58 | 9 | 
| 333.3/128.1 | 81 | ||||
| D-GA6 | ISTD | [M-H2O+H]+ | 331.3/285.3 | 104 | 9 | 
| 331.3/303.1 | 9 | ||||
| GA6 | [M-H2O+H]+ | 329.3/283.3 | 104 | 9 | |
| 329.3/301.1 | 9 | 
Disclaimer/Publisher’s Note: The statements, opinions and data contained in all publications are solely those of the individual author(s) and contributor(s) and not of MDPI and/or the editor(s). MDPI and/or the editor(s) disclaim responsibility for any injury to people or property resulting from any ideas, methods, instructions or products referred to in the content.  | 
© 2023 by the authors. Licensee MDPI, Basel, Switzerland. This article is an open access article distributed under the terms and conditions of the Creative Commons Attribution (CC BY) license (https://creativecommons.org/licenses/by/4.0/).
Share and Cite
Simlat, M.; Ptak, A.; Jaglarz, A.; Szewczyk, A.; Dziurka, M.; Gurgul, A. Seeds of Stevia rebaudiana Bertoni as a Source of Plant Growth-Promoting Endophytic Bacteria with the Potential to Synthesize Rebaudioside A. Int. J. Mol. Sci. 2023, 24, 2174. https://doi.org/10.3390/ijms24032174
Simlat M, Ptak A, Jaglarz A, Szewczyk A, Dziurka M, Gurgul A. Seeds of Stevia rebaudiana Bertoni as a Source of Plant Growth-Promoting Endophytic Bacteria with the Potential to Synthesize Rebaudioside A. International Journal of Molecular Sciences. 2023; 24(3):2174. https://doi.org/10.3390/ijms24032174
Chicago/Turabian StyleSimlat, Magdalena, Agata Ptak, Anita Jaglarz, Agnieszka Szewczyk, Michał Dziurka, and Artur Gurgul. 2023. "Seeds of Stevia rebaudiana Bertoni as a Source of Plant Growth-Promoting Endophytic Bacteria with the Potential to Synthesize Rebaudioside A" International Journal of Molecular Sciences 24, no. 3: 2174. https://doi.org/10.3390/ijms24032174
APA StyleSimlat, M., Ptak, A., Jaglarz, A., Szewczyk, A., Dziurka, M., & Gurgul, A. (2023). Seeds of Stevia rebaudiana Bertoni as a Source of Plant Growth-Promoting Endophytic Bacteria with the Potential to Synthesize Rebaudioside A. International Journal of Molecular Sciences, 24(3), 2174. https://doi.org/10.3390/ijms24032174
        
